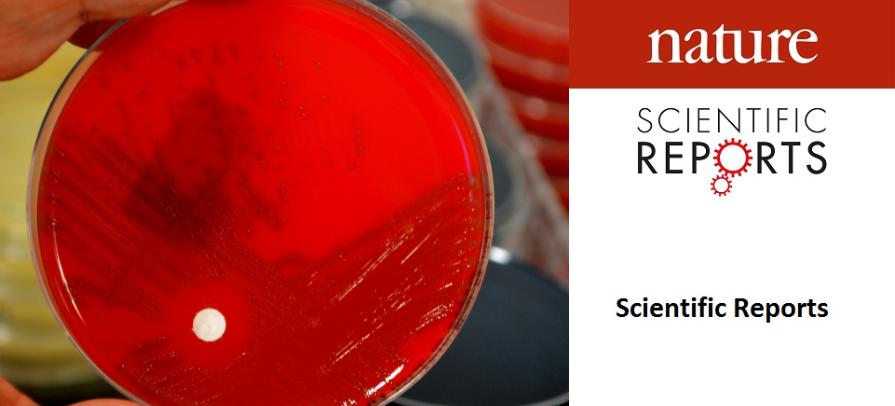
Streptococcus B

Títtleikakanning og genomkanning av B streptokokkum í Føroyum
Óli Joensen, masterlesandi í Molecular Health Science á Roskilde Universitet, nýtti sína bachelor ritgerð, sum nú verður útgivin sum grein, at gera eina epidemiologiska og genetiska analysu av støðunu viðviðvíkjandi “Streptococcus agalactiae” ella “Gruppe B streptokokkum” í Føroyum. Hendan greinin er tann fyrsta av sínum slag í Føroyum, og greinin er almannakunngjørd í tíðarritinum Scientific Reports hjá Nature.
Óli Joensen sigur soleiðis um kanningina og greinina:
"“Streptococcus agalactiae” eisini nevnt “GBS” er ein bakteria, sum í flestum førum er kend fyri at kunna elva til álvarsliga sjúku hjá nýðføðingum og/ella mammuni. Tó kann GBS eins væl elva til álvarsliga sjúku hjá eldri og borgarum við niðursettari ímmunverju. GBS er ein vanlig bakteria í okkara tarmfloru, har millum 10%-30% av fólkum eru berarar, tó seinastu árini hevur verið ein øking av invasivum GBS tilburðum millum eldri í háinntøkulondum sum t.d. Føroyum. Tí vildu vit gera eina epidemiologiska analysu av øllum skrásettum invasivum GBS tilburðum í Føroyum og samanbera teir við onnur norðurevropeisk lond, so sum Danmark og Norra. Eisini varð gjørd ein genetisk kanning av GBS isolatum frá 2020-2024.
Í kanningini savnaðu vit øll tøl saman, sum vit kundu finna frá bæði Landssjúkrahúsinum og Statens Serums Institut (SSI), sum vóru frá 2009-2024. Bakteriuisolatir frá SSI vóru frá 2020-2024, har vóru eisini genomiskar dátur við serotypum og membran-proteinum, ið verða nýttar til menning av koppingarevni, umframt gen, ið koda fyri mótstøðuføri yvirfyri nýttum antibiotikum.
Hvat funnu vit útav?
Sjúkutilburðir í Føroyum kunnu sýnast at vísa eina hækkandi tilgongd frá áleið 2019-2024, sum líkist tølum frá grannalondum okkara.
- Tey koppingarevni, sum í løtuni eru í gerð, síggja út til at verja móti teimum serotypum/ proteintypum í GBS, ið vit finna í Føroyum.
- Mótstøðuførið er eisini til staðar í Føroyum, eins og í grannalondunum, tó yvirfyri teimum alternativu antibiotikunum, í fall at ein sjúklingur er ovurviðkvæmur fyri fyrsta valinum, sum oftast er vanligt penicillin.
Hvat merkir hetta?
Spurningurin er so, um tilburðir hava verið hækkandi síðani 2019, ella um vit blivu betri at kanna føroyingar um tað mundið, orsakað av COVID-19 farsóttini frá áleið 2020-2022. Eisini er ein statistisk óvissa í Føroyum, av at vit eru so fá. Hvør tilburður vektar nógv, um vit umrokna til “tilburðir pr. 100.000” og samanbera við eitt nú Danmark.
Vit kunnu vænta, at tær koppsetingarnar, ið eru ávegis, sannlíkt vilja veita nøktandi verju, og koppingarevni vera klár innan fá ár.
Hóast tað er torført at koma til eina ítøkiliga niðurstøðu, kann hendan greinin virka sum eitt grundarlag til komandi kanningar av GBS í Føroyum."
Greinin er úrslit av samstarvi millum lesandi og granskarar á Roskilde Universitet, Sjúkrahúsverkinum í Føroyum og Statens Serum Institut.
Greinin kallast “A nationwide study of invasive Streptococcus agalactiae in the Faroe Islands from 2009 to 2024” og kann lesast her
Høvundar eru: Óli Joensen, Karen Angeliki Krogfelt, Shahin Gaini & Hans-Christian Slotved
Hetta er fyrsta vísindagrein hjá Óla Joensen, ið eisini var hansara bachelor ritgerð.